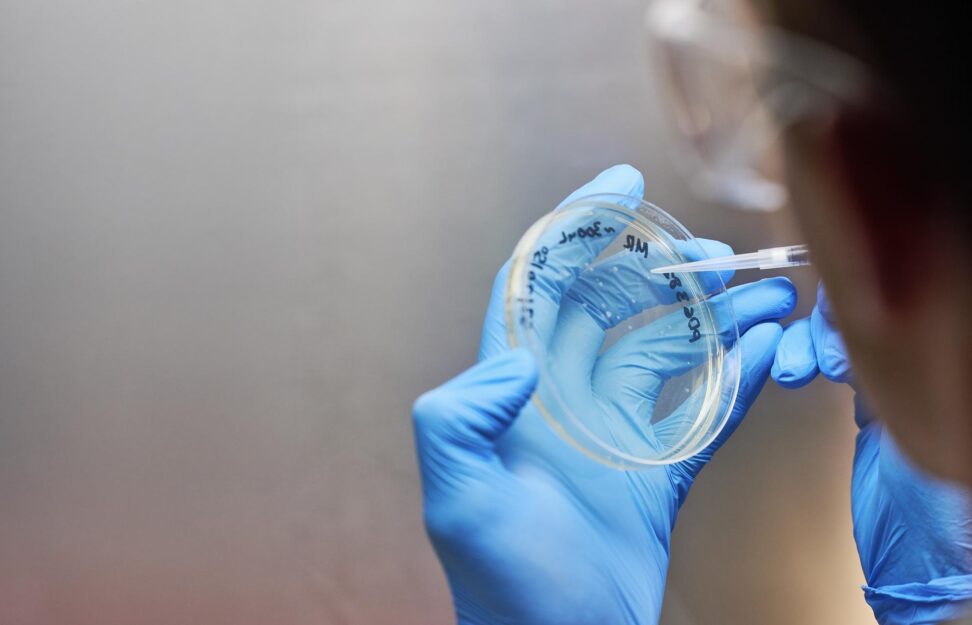

Study with us
Be trained by our world-class medical researchers to make discoveries that have a positive impact on the health and welfare of our community.
Available projects

The evolution of cancer cell clones
Projects: Honours or PhD
Project details
Primary Supervisor: Associate Professor Guy Lyons
Supervisory Team: Guy Lyons, Mojdeh Abbasi
Centre: Cancer Innovations
Cancers are causes by mutations in key regulatory genes that promote tumour growth and dissemination. Most tumours are multiclonal, being comprised of cells that have different mutations from other cells within the tumour. It is known that a high level of this genetic heterogeneity predicts poor patient outcomes, but the reason is not known. One possible reason is that different clones within a tumour have complementary mutations that enable them to behave more malignantly when they are together than when they are present as individual clones. This project investigates the role of symbiotic interactions between clones of cells in driving tumour progression. It uses live cell microscopy, molecular analyses and gene editing to identify what types of genes can interact in different individual cells. Computer simulations are used to predict the effects of these cell-cell interactions on the population of cells as a whole, and how they affect the clonal evolution of the cells.

Treatment of corneal blindness using stem cells
Projects: Honours or PhD
Project details
Primary Supervisor: Associate Professor Guy Lyons
Supervisory Team: Guy Lyons, Seaky Lim, Mojdeh Abbasi
Centre: Cancer Innovations
Blindness from corneal disease affects 10 million people globally. The outermost layer of cells that cover the cornea are critical to its clarity and are produced by stem cells at its edge, called limbal stem (LS) cells. LS cell deficiency can be caused by trauma, infection or faulty genes, and is a major cause of blindness. We have developed a method for transplanting LS cells onto affected eyes via special contact lenses. However, the source remains problematic: obtaining LS cells from the other eye carries risk for that eye, and donor LS cells are often suffer immune rejection. The derivation of LS cells from patient-derived induced pluripotent stem (iPS) cells could overcome these problems. iPS cells are obtained by “re-programming” blood cells into a state that can give rise to multiple cell types. As a proof of principle of our approach, we have recently shown that iPS cells can be converted into LS cells by treating them with a special cocktail of drugs and proteins. To translate this method to the clinic, we now need to increase the efficiency of this process and enable it to occur on our special contact lenses, so that they can be transplanted safely and with ease.

Targeting Neuroinflammation with Novel Epigenetic Drugs
Projects: Honours, Masters & PhD
Project details
Primary Supervisor: Dr Mehdi Sharifi Tabar
Supervisory Team: Dr Chuck Bailey
Centre: Rare Diseases & Gene Therapy
Central nervous system-related autoimmune diseases, such as Aicardi-Goutières syndrome, and systemic conditions like Sjögren’s syndrome and systemic lupus erythematosus, are driven by the persistent overactivation of interferon-stimulated genes (ISGs). This persistent ISG activity causes inflammation and can lead to brain tissue damage. Currently, there are no effective treatments, highlighting an urgent need for innovative therapies. Our recent research has identified TRIP (Transcriptional Regulator of the Interferon Pathway) as a key epigenetic regulator of neuroinflammatory ISG expression, making it a highly promising therapeutic target for these diseases.
In this project, using a multidisciplinary approach, combining molecular, cellular, biochemical, and genetic experiments, we aim to examine two new immunoregulatory drugs that selectively target TRIP mRNA and protein to suppress neuroinflammatory ISGs.
* For intellectual property reasons, we have named the gene TRIP

Identifying Circulating Tumour Cells through patient liquid biopsies
Projects: Honours, Masters & PhD
Project details
Primary Supervisor: Dr Dannel Yeo
Supervisory Team: Anna Leach, Christine Lee
Centre: Cancer Innovations
Our laboratory aims to improve low surviving cancers (pancreatic cancer, small cell lung cancer, mesothelioma, peritoneal, appendiceal, and colorectal cancer) through a personalised approach using liquid biopsy (circulating tumour cells) and patient-derived organoids (3D culture models). We utilize next generation liquid biopsy technology to detect and isolate rare cancer cells in the blood as a diagnostic and prognostic biomarker. Through single-cell characterisation, we can obtain molecular insights in a non-invasive manner. We also explore novel therapies such as targeted therapy and CAR-T cellular immunotherapy to target cancer vulnerabilities and obtain cures. We work closely with our clinical collaborators at Royal Prince Alfred Hospital and Chris O’Brien Lifehouse to ensure our findings have the best possible outcomes for cancer patients. Our translational research projects can be tailored to suit Honours, Masters or PhD degrees

Investigating proteases in chronic liver disease and hepatocellular carcinoma
Projects: Honours
Project details
Primary Supervisor: Dr. Bobby Boumelhem
Supervisory Team: Professor Mark Gorrell; Dr. Jiali Carrie Huang
Centre: Cancer Innovations
Primary liver cancer is the 5th leading cause of cancer related deaths in Australia with incidence rates increasing yearly. The pathogenesis of chronic liver injury and cancer is driven by chronic cell death, proliferation and inflammation. Proteases are enzymes that cleave peptide bonds within proteins, often with regulatory outcomes in physiological and pathological processes. Proteases can regulate the structure, localization and function of many proteins, and influence protein-protein or protein-cell interaction crucial in disease pathogenesis, including cirrhosis and cancer. As such, our lab is keenly interested in the dipeptidyl peptidase (DPP) family of enzymes in chronic liver disease including cirrhosis and hepatocellular carcinoma. Fibroblast activation protein alpha (FAP), a member of the DPP family, is a unique protease with increase abundance in abnormal human tissue, especially in tissue-remodelling that occurs in injury, fibrosis and tumours. A project will be derived based on student’s interests in chronic liver disease and/or liver cancer. We are equipped with multiple mouse models of chronic liver disease including liver cancer as well as treatment with exciting and novel pan-DPP inhibitors.

Mechanisms of epithelial stratification
Projects: Honours or PhD
Project details
Primary Supervisor: Associate Professor Guy Lyons
Supervisory Team: Guy Lyons, Mojdeh Abbasi
Centre: Cancer Innovations
The epithelial cells that cover the surfaces of our skin, corneas and oral mucosa are multilayered, or “stratified”. This provides physical strength to resist abrasion and forms a barrier to the movement of molecules, microorganisms and UV radiation. In contrast, the “simple” epithelial cells that line the intestines, lungs and glandular tissues grow as a single, 2-dimensional layer. This simple growth pattern is relatively fragile, but facilitates the rapid passage of molecules across it. Thus, the ability to grow as a 3-dimensional array of cells is the characteristic that defines the distinction between these two fundamental types of epithelia, but the cellular mechanisms that regulate stratification are poorly understood. Mutations in the genes that regulate epithelial stratification could conceivably contribute to epithelial cancers by enabling inappropriate stratification without the blocks to cell replication that normally accompany it. In this project, the student will investigate epithelial stratification using a human corneal epithelial cell line grown in culture. The roles of particular genes in epithelial stratification will be determined by altering their expression using gene editing and/or RNA interference approaches. The degree of stratification and organisation of the cells will be determined from live cell imaging and immunofluorescent staining combined with advanced laser-based microscopy techniques.

Directed evolution of liver hormones to enhance metabolism
Projects: Honours & PhD
Project details
Primary Supervisor: Associate Professor Daniel Hesselson
Supervisory Team: Dr Alex Cole
Centre: Biomedical AI
The hormone FGF21 is being developed as a therapy for type 2 diabetes and fatty liver with clinical trials showing promise for improving metabolic health including lowering liver fat and blood cholesterol. Natural FGF21 has a short-half life which has been extended by protein engineering to resist degradation or clearance from the body. However, stabilised FGF21 variants are typically less potent. This project will apply cutting edge directed evolution approaches to enhance the signaling activity (potency) of FGF21. The primary expected outcome is to produce a superior FGF21 molecule that could be commercialised as a fatty liver and/or diabetes therapy.

Enhancing the durability of stem cell-derived islets for type 1 diabetes
Projects: Honours & PhD
Project details
Primary Supervisor: Associate Professor Daniel Hesselson
Supervisory Team: Lise Hunault
Centre: Biomedical AI
Type 1 diabetes (T1D) results from the autoimmune destruction of insulin-producing beta cells, requiring continuous management of blood sugar levels. A lifelong cure for T1D will require regeneration or replacement of these cells. This project focuses on the transcription factor PDX1, which is a master regulator of pancreatic cell fate and is also essential for promoting optimal beta cell function. Excitingly, PDX1 both promotes regeneration and is critical for converting other pancreatic cell-types into beta cells. Our team uses directed evolution to engineer novel proteins in cells that model human disease. We have developed PDX1 variants with new properties that could enhance the function of stem cell-derived islets, which are the only renewable source of beta cells for curing T1D. The goal of this project is to determine which variant has the most potential for increasing the durability and function of transplanted islets, setting the stage for clinical translation.

Novel delivery systems to empower complete repair after a heart attack
Projects: Honours & PhD
Project details
Primary Supervisor: Associate Professor Daniel Hesselson
Supervisory Team: Manuela Florido
Centre: Biomedical AI
Myocardial infarction (MI) results from the sudden loss of blood flow to cardiac tissue, causing massive cardiomyocyte death and subsequent scar formation that impairs pump function. Current clinical interventions stabilise patients and limit further damage but cannot regenerate lost myocardium. This project targets that unmet need by engineering protein therapeutics and delivering them at the optimal time and place to maximise cardiomyocyte survival, proliferation, and neovascularisation. Using our directed evolution and rational design platform, we have already generated lead protein candidates. The aim of this research is to deliver these candidates in in vitro human cardiomyocyte cultures and in vivo rodent MI models to identify the most potent regenerators, setting the stage for future preclinical and clinical translation.

Tumour-activated cancer immunotherapies
Projects: PhD
Project details
Primary Supervisor: Associate Professor Daniel Hesselson
Supervisory Team: Dr Alex Cole
Centre: Biomedical AI
Solid tumours create an immunosuppressive microenvironment that limits the efficacy and safety of current immunotherapies, often leading to poor efficacy and off-target toxicity. This project aims to engineer next-generation protein and cellular therapies that are triggered by tumour-restricted signals such as hypoxia, acidic pH, or matrix metalloproteinase activity. Using our directed evolution and rational protein design platform, you will develop and test novel therapies in cell-based models, then evaluate them for safety and therapeutic benefit in mouse models of solid cancer. The goal of this research is to identify the most promising tumour-activated immunotherapeutics, laying the groundwork for more potent and less toxic cancer treatments.

Applying genetic risk algorithm to identify patients at high risk of chronic liver diseases
Projects: PhD
Project details
Primary Supervisor: Clinical Professor Devanshi Seth
Supervisory Team: Clinical Professor Devanshi Seth
Liver cirrhosis is one of the most common life-threatening diseases. Alcohol misuse is the major cause of alcohol-related cirrhosis (ALC), followed by the metabolic dysfunction-associated steatotic liver disease (MASLD), affecting a quarter of global adults. ALC contributes to approximately half of all liver disease related mortality with a median survival post-hospital admission of 2.5 years, worse than that of many cancers. Both ALD and MASLD are preventable if detected early. But patients remain asymptomatic until advanced disease presentation, making it difficult for clinicians to predict who are at a greater risk of preventable cirrhosis and its complications, causing loss of productivity, illness, health care utilisation and death.
Genetic susceptibility to liver diseases is recent knowledge with evidence of shared genetic risks between ALC and MASLD. Our genomic studies in ALC recently developed genetic algorithms combining clinical risk (diabetes) that can predict a 10-fold increased cirrhosis risk in drinkers (PMC8803006) and a polygenic risk score (PRSALC) that also identifies high-risk MASLD patients (PMC11093576). This new knowledge allows us to identify people at the highest risk of progressive liver damage. However, genetic testing for liver diseases is not currently practiced leaving a gap in early identification and treatment of high-risk patients.
With my team of multidisciplinary clinicians, geneticist and genetic statisticians we aim to (i) investigate the prevalence of cirrhosis risk alleles in diverse populations using publicly available genetic databases (UK Biobank, Medical Genome Reference Bank) and (ii) test our algorithms for risk prediction as a follow-up in our existing GenomALC and UK Biobank cohorts of drinkers. Knowing the genetic risk prevalence in diverse populations and predictability of risk algorithms has high potential of developing and evaluating the best individualised value-add treatment for the two most prevalent liver diseases.

A novel nanoparticle platform targeting hepatic lipotoxicity to attenuate fatty liver diseases
Projects: PhD
Project details
Primary Supervisor: Clinical Professor Devanshi Seth
Supervisory Team: Professor Marcela Bilek, Dr Bobby Boumelhem
Build-up of liver lipid is the first hallmark of initiation of chronic liver diseases. There is compelling evidence that fatty liver, with persistent lipid excess induces lipotoxicity, a major risk for fibrosis, cirrhosis and cancer (PMC6888337). Current pharmacological treatments focused on targeting established liver diseases remain abysmal, limited by high costs and side effects. Fatty liver diseases are reaching epidemic proportions globally, current therapies are unlikely to benefit at population level underscoring an unmet need to invest in novel directions for preventive and cost-effective therapies. New knowledge from genome wide association studies (GWAS) show that most alleles associated with risk of cirrhosis reside in genes with functions in lipid droplet biology and/or lipid metabolism, strongly linking genetic susceptibility to lipotoxicity (PMID: 32853455, PMC8803006). Thus our novel strategies proposed in this project are to (i) develop dietary nutrients (such as L-carnitine, caffeine, paraxanthine, naringenin) as therapeutic agents targeting downstream dysregulated lipid pathways associated with risk variants, and (ii) develop Plasma Polymerised Nanoparticles (PPNs) as unique drug delivery platforms to target the root cause, i.e. excess lipid driven hepatic lipotoxicity. Our team collaborators have novel IP protected ‘histochemions’, PPNs linked to Nile Red (NR) a lipophilic dye that binds to neutral lipids such as triglycerides and cholesterol, that preferentially steer histochemions towards enriched TG and cholesterol, and Nile Blue (NB) that binds to fatty acids. We have preliminary data that these histochemions can simultaneously bind to multiple cargoes covalently, including dietary nutrients and hepatocyte homing molecules (albumin, indocyanin green, asialoglycoprotein receptor), allowing specific drugs to be linked for targeting lipids and lipid pathways in the liver. This project will advance these findings, optimise delivery and intervention protocols and test the functionality of modified PPN-based drug delivery platforms in vitro (cell culture) and in vivo in our customised pre-clinical CRISPR-Cas9 risk gene depletion models of fatty liver in zebrafish (PMID37650211). Use of nutrients are already in the disease management guidelines adjunct to other therapies, as early-stage therapeutic agents. The proposed dietary nutrients are known to reduce hepatic lipotoxic injury (inflammation, mitochondrial and oxidative stress) with zero-minimal toxicity, and are the choice of drugs in this project. Our multidisciplinary team expertise in nanotechnology, genetics, biomedical engineering, lipidomics, liver diseases and clinical hepatology, preliminary data, IP protected nanoparticle platform, pre-clinical models, established protocols, core facilities (zebrafish husbandry, flow cytometry, confocal imaging) and conducive work environment, we are best placed for the successful completion of this project. This project is highly likely to generate new IP/patents and has the potential to open up avenues for exploring cost-effective therapies targeting early stages of fatty liver to prevent disease progression. Techniques: Nanotechnology, lipidomics, zebrafish husbandry, flow cytometry, confocal imaging, molecular biology, CRISPR-Cas9. Funding is being sourced through grant applications in review/to be submitted.

The role of sex chromosomes in melanoma survival
Projects: Honours, Masters & PhD
Project details
Primary Supervisor: Dr Jessamy Tiffen
Supervisory Team: Dr Cindy Tseng
Centre: Cancer Innovations
Men are more than twice as likely to die from melanoma compared to women, and our research aims to uncover why. We propose that genes located on the sex chromosomes may play a critical role in shaping the body’s ability to combat cancer, potentially explaining the survival advantage seen in women. Our team has identified several X and Y chromosome-linked genes implicated in anti-tumour responses, but the mechanisms behind their protective effects remain unclear. Using cutting-edge technologies such as CRISPR and Genetically Engineered Mouse Models, we are investigating how these genes function in both melanoma and immune cells through advanced pre-clinical models. Students joining this project will gain hands-on experience in cell and molecular biology, working with sophisticated in vitro and in vivo melanoma systems. Collaborating closely with clinicians from Melanoma Institute Australia, our research is designed to have real-world impact and translational relevance. Projects can be tailored to suit Honours, Masters, or PhD degrees, offering a unique opportunity to contribute to life-saving cancer research

Understanding tuberculosis vaccines
Projects: PhD & Honours
Project details
Primary Supervisor: Professor Warwick Britton AO & Professor Angelo Izzo
Supervisory Team: Linda Izzo
Centre: Infection & Immunity
To develop new tuberculosis vaccines we need to better understand the triggers associated with innate immune cell activation. This project will examine the early interactions between vaccine components and cells of the innate immune response.

Novel newborn vaccines for the prevention
of tuberculosis
Projects: PhD & Honours
Project details
Primary Supervisor: Professor Warwick Britton AO
Supervisory Team: Professor Angelo Izzo and
Dr Isaac G. Sakala
Centre: Infection & Immunity
Tuberculosis (TB) remains one of the deadliest infectious diseases worldwide, and the rise of
multi-drug-resistant strains of Mycobacterium tuberculosis (Mtb) exacerbates the situation.
Although the Bacillus Calmette-Guérin (BCG) vaccine has been used for over 100 years as
the standard TB vaccine for newborns, it is only partially effective and has had limited impact
on global TB control. A successful TB vaccine for newborns could dramatically transform
global control efforts by significantly reducing TB-related illness and death. We are
developing novel multistage TB vaccines using various new-generation adjuvants that induce
protective immunity against pulmonary Mtb infection in adult mice. Our previous research
has shown that these adjuvants promote protective immunity when used in inactivated and
subunit influenza vaccines in newborn mice.
This student project aims to explore various combinations of new adjuvants and Mtb protein
subunit antigens in an innovative model of newborn immunisation for protection against
pulmonary Mtb infection. These studies will investigate the early and long-term immune
responses induced by different protein/adjuvant vaccines in newborn mice and determine
how these responses correlate with protective efficacy against aerosol Mtb challenges.
Opportunities: The project will provide extensive training in cellular immunology including advanced immunophenotyping of innate and adaptive immune cells using flow and mass cytometry, multiplex cytokine assays and scRNA-Seq technology. The student will be part of an international network of scientists conducting cutting edge vaccine antigen/adjuvant and drug discovery research, vaccine
research and development, and contributing to the global control of TB epidemic.
Student benefits
- Inclusion and Gender Equity Program
- Grant Application Support
- Visiting Speaker Initiative
- Weekly Seminars & Lunches
- Unconscious Bias Training

Scholarships
Biomedical AI PhD Awards
The purpose of these top-up scholarships is to support exceptional PhD students interested in applying cutting-edge computational and directed evolution approaches to produce novel therapeutics. Scholarships are available for PhD projects focused on cardiovascular disease or cancer. An annual top-up stipend of $20,000 (up to three years) will be offered to scholars who receive a Research Training Program (RTP, or equivalent) scholarship. For more information and to apply please contact biomedicalAI@
centenary.org.au
Please refer to the USYD website: https://www.sydney.edu.au/scholarships/
Please refer to the UTS website: https://www.uts.edu.au/study/scholarships
FAQs
Top scholarships are subject to discussions with your supervisor.
We would first recommend you make contact with a supervisor at Centenary. Getting a relevant visa can take some time so it is important to factor this into your application timeline. We suggest submitting a completed application six months before you want to commence and if you’re successful, you can then apply for your visa.
For the University of Sydney, please refer to the website: https://www.sydney.edu.au/study/applying/how-to-apply.html
For the University of Technology Sydney, please refer to the website: https://www.uts.edu.au/for-students/admissions-entry/how-to-apply
Application and semester dates can be found on the University of Sydney or University of Technology Sydney websites.
University of Sydney: https://www.sydney.edu.au/study/applying/application-dates.html
University of Technology Sydney: https://www.uts.edu.au/for-students/admissions-entry/application-dates
Get in touch
For any enquiries on our student opportunities, scholarship program or study opportunities at Centenary, please email us and we will get back to you as soon as possible.



